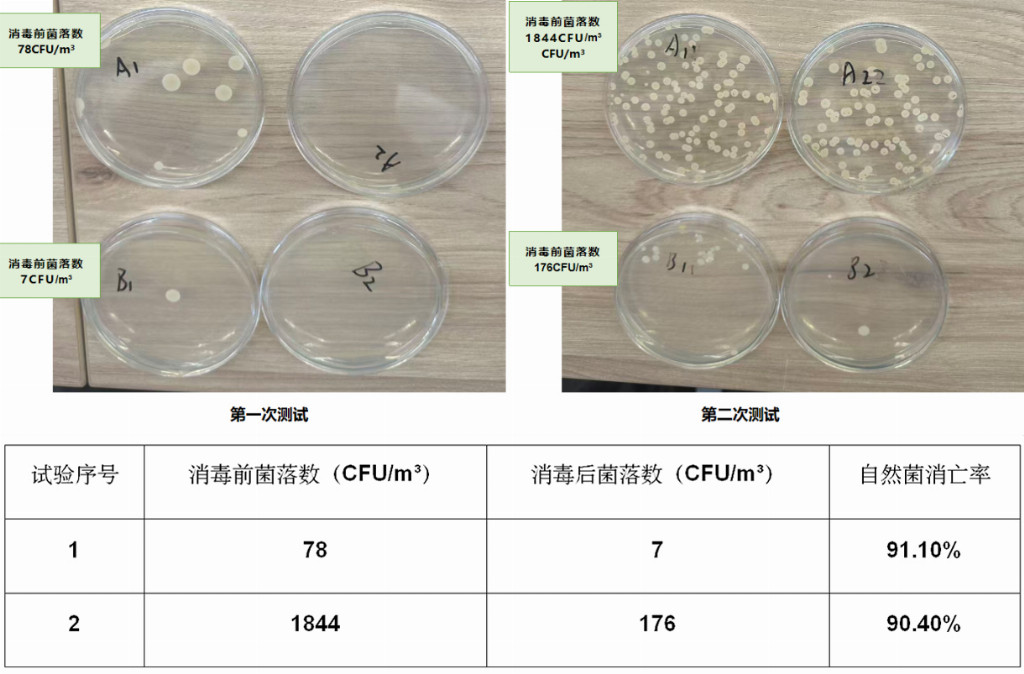

财经头条
3D Printing in China Grows 30% Annually—DonR...
Formnext Asia Shenzhen returns from 26 – 28 August 2025, continuing its role as a trusted ...
【超越五星健康车】医疗级防护方案重磅推出,引领健康汽车新潮流
发布时间:2025/10/25 财经头条 浏览:324
随着社会经济的发展与人民健康意识的提升,人们对车内空气质量提出了更高要求。其中,车内空气中的微生物(尤其是有害微生物)、甲醛及 PM2.5 等污染物,作为危害人体健康的最常见指标,直接威胁驾乘者呼吸系统、皮肤健康。其不仅备受行业内各大厂家的重点关注,也成为广大车主购车、用车时的核心考量因素。

在此背景下,如何依托科学技术手段,高效净化消除这些污染物、从源头避免其对人体产生伤害,已成为契合市场需求、顺应 CN – 95、C – AHI 五星级座舱标准的行业焦点。苏州佰仕朗智能科技有限公司作为国际领先的医用空气消毒设备研发企业,创新性地推出“车载消毒净化模组”,为汽车搭载了“医疗级防护”的空间消毒净化能力,并率先与德鑫汽车空调就车内空气治理问题展开深入研究。近期,双方联合发布实车测试报告,深度验证车内核心污染物的净化效能,为健康汽车领域注入新活力。

测试选用甲醛、PM2.5、细菌作为核心测试指标,它们分别对应致癌挥发物、可吸入颗粒、生物污染 三类最突出的健康风险。国家工业和信息化部、中国汽车技术研究中心、中国汽车工程研究院等部门及机构,针对车内空气质量分别提出了 CN – 95 和 C – AHI 五星级座舱技术标准,其重点主要集中在甲醛、PM2.5 等污染物指标上。其中,最高等级的甲醛指标要求车辆在常温静态下车内空气中甲醛含量低于 0.015mg/m³,该指标远低于国家卫生健康委员会发布的室内空气质量 0.08mg/m³ 标准。形象地说,符合最高标准的车内空气比室内空气更洁净;而 PM2.5 的要求是在 2 分 30 秒内将指标降至 35μg/m³ 以下,即实现从 “烟雾缭绕” 到 “洁净清新” 的快速转变。

目前,国内已有数十款车型获得五星级座舱评级,但该评级目前未纳入微生物指标要求,且国内尚未出台具有权威性的车内微生物标准。

这意味着即便车主选择了 “五星座舱” 车型,仍可能暴露在微生物污染的健康隐患中,而佰仕朗依托医用技术研发的车载消毒净化模组,正是为解决这一未被覆盖的风险而来。其与芜湖德鑫汽车空调联合发布实车测试报告,用数据验证该模组在微生物净化领域的效能,为行业提供了可参考的解决方案。

测试一:甲醛去除测试
佰仕朗“消毒净化模组”安装在试验车上运行 90min 后,满足 “健康座舱” P3 目标中关于甲醛的要求,即常温下甲醛浓度≤0.015mg/m³。

测试结果远优于国标(甲醛浓度≤0.1mg/m³),实现从 “被动合规” 到 “主动医疗级防护” 的跨越,树立了 “实时净化 + 长效防护” 的技术标杆。
测试二:颗粒物PM2.5去除测试
佰仕朗 “消毒净化模组” 安装在试验车上运行期间,3 次 PM2.5 去除测试的用时均≤2.5min,满足 “健康座舱” P3 的颗粒净化目标。

数据显示,3次PM2.5 浓度从 500μg/m³ 降至 35μg/m³ 的用时,显著优于五星健康座舱标准,净化效率表现突出。
测试三:微生物(自然菌)消毒杀菌测试
佰仕朗 “消毒净化模组” 安装在试验车上运行 120min 后,对空气中自然菌的各次试验消亡率均≥90%,符合国家卫生部(现卫健委)发布的《消毒技术规范》(2002 版)要求。
当前通用的车内空气管理方案,多侧重通过材料管控构建基础健康座舱环境。而佰仕朗的技术更聚焦于车内空气的 “动态消毒净化”, 不仅能实现自然菌消亡率≥90%,还可保持 24 小时高效消杀。更关键的是,其在强效消杀的同时,创新实现了 “不用紫外线、不产生臭氧” 的人机共存技术方案,彻底规避了市场上多数消毒技术 “虽解决污染问题,却引入新安全隐患”(即 “倒了脏水又可能留不住孩子”)的缺陷。
佰仕朗车载消毒净化模组以可见光催化纳米材料技术为核心,真正实现人机共存,其消杀效率、安全性、场景适应性等维度全面达到甚至超越五星健康座舱标准,为汽车行业提供了可量化、可验证的 “医疗级空气管理方案”。

苏州佰仕朗智能科技有限公司是一家成立于 2018 年的国家高新技术企业。其生产的医用空气消毒机,已广泛应用于数百家三甲医院、学校、政府机关等场所。佰仕朗车载消毒净化模组,依托医用空气消毒机的核心可见光催化技术,具备 “安全无紫外、人机共存、长效杀菌” 的优势,为车载场景提供医疗同级净化保障。该同款核心技术产品已通过卫健委备案认证,此前已应用于医院等专业场景,可实现对冠状病毒、肺炎支原体等病原体的高效清除。

芜湖德鑫汽车空调有限公司是一家专业从事汽车热管理系统研发、销售及制造的高新技术企业,业务范围已覆盖多种新能源汽车领域,且已与行业内多家头部汽车主机厂建立长期合作关系,连续多年荣获 “优秀供应商” 称号,在行业内位居前列。

此次佰仕朗与德鑫汽车空调的联合测试,不仅验证了佰仕朗车载消毒净化模组在现有汽车空调及座舱空气净化消毒技术领域的领先性,更为行业带来多重价值:一方面为车主提供了切实的健康保障,打造更安全、健康的车内环境;另一方面明确了未来健康汽车的发展方向,为行业及相关部门制定车内空气消毒规范提供了可行性技术方案与数据依据。

联合测试报告的发布,有望推动更多企业投入健康汽车研发,促进行业绿色健康发展。在汽车制造商、技术供应商及相关监管机构的协同努力下,未来将涌现更多创新技术,行业标准也将进一步完善 —— 最终确保每一位车主都能享受到真正意义上的健康汽车生活,并推动健康汽车成为市场新趋势,引领整个汽车行业向更绿色、更安全的方向迈进。让我们共同期待健康驾驶新时代的到来!